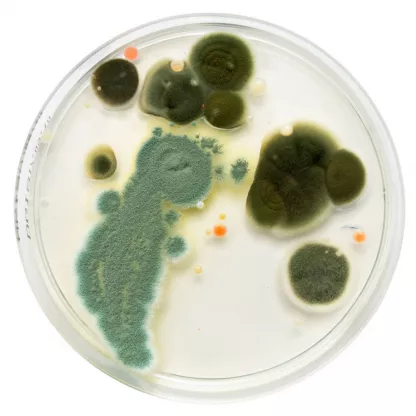

Pojav plesni je plod različnih dejavnikov. In te dejavnike je potrebno raziskati še preden se lotimo odstranjevanja plesni, saj nočemo, da bi se nam plesen kar naprej ponavljala.
Ugotoviti je torej potrebno pogoje za nastanek plesni, definirati najpogostejše vzroke, izvore vlage v prostoru in načine odstranjevanja plesni.
Potem pa uporabiti rešitev, ki najbolj ustreza tem pogojem.
Plesen je naravni sestavni del našega ekosistema in je v nekem naravnem ravnotežju z drugimi mikroorganizmi, v zunanjem okolju, popolnoma neškodljiva.
Problem pa nastane, ko se plesen pojavi v notranjih prostorih...
...kjer vemo, da je običajno notranji zrak toplejši in zato tudi bolj vlažen.
In ravno obdobje vlage v zraku in prve ohladitve, ki jih navadno občutimo jeseni in pozimi, ustvarjajo odlične pogoje za razvoj plesni.
In ker navadno v prvih hladnih mesecih prostora še ne ogrevamo v zadostni meri, se zaradi hladnega zraka, vlažnost v prostoru poveča in tako pride do pojava kondenzacije na kritičnih mestih, kot so:
Zid za omaro
Okenskih policah in nosilcih
Spodnja stran jogija
Toplotni mostovi
Severna stena.
In posledično se na tistih mestih skoraj zagotovo pojavi plesen.
Zdravju škodljive posledice ob stiku s plesnijo
Prekomerni razvoj plesni v notranjih prostorih ima lahko znatne posledice na zdravje prebivalcev teh podvrženih prostorov.
Plesen se razmnožuje s sporami ali s konidiji, ki se pri najmanjšem prepihu dvignejo ter lebdijo v zraku naših domov.
In ob povečanem številu le teh se lahko pri osebah dovzetnih za alergije pojavijo zelo močne alergije.
Poleg tega pa lahko plesen pri osebah z oslabljenim imunskim sistemom (dojenčki, bolniki, starejši, itd.) močno vpliva na dihalne poti.
Oct 16, 2024